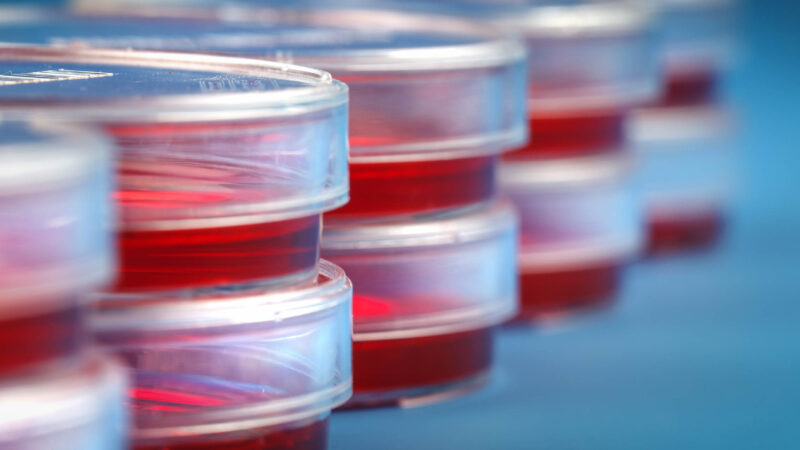
petri dishes

We combine scientific expertise with agile, accredited manufacturing across custom media, high-quality reagents and serum, biospecimens, antibody generation, and kitting services.
We further your science.
LSG is a specialist UK-based full service CDMO for media and liquid solutions.
From concept to scale, we work with you to manufacture your custom media and liquids in a cGMP-grade facility to the highest quality.
Sera, culture media, buffers, and transport media produced to the highest standards to support your research.
Custom monoclonal and polyclonal antibody services, antigen sourcing, peptide synthesis and more, from concept to delivery.
We offer one of the most comprehensive ranges of biological specimens in Europe.
Featured products
-
 £52.09 – £546.45Price range: £52.09 through £546.45
£52.09 – £546.45Price range: £52.09 through £546.45LSG can source material from the following countries – Brazil,...
- Select options This product has multiple variants. The options may be chosen on the product page
-
 £55.56 – £798.69Price range: £55.56 through £798.69
£55.56 – £798.69Price range: £55.56 through £798.69T-STORE ® (Tissue Store) is an innovative, sterile, chemically defined...
- Select options This product has multiple variants. The options may be chosen on the product page
Our customers and partners

"Many thanks for all your help and excellent service as always. "

"I'm very pleased with the service, so thank you very much!"

"It has been really nice working with LSG on this work."

"Very efficient customer service."

"Thank you so much. Very good and fast work."

"Everything looks great with the health cert. Thank you for all that you do."

"I really appreciate your prompt responses and the high quality of your products and service."
Customer Case Study
ProtonDx was looking for a partner to handle the precise task of filling tubes with liquid, sealing them and packaging the kits for distribution. LSG provided full support, managing every step from initial consultation and setup to quality control, logistics and even final shipping to ProtonDx’s customers. A great example of LSG’s breadth of capabilities and desire to develop integrated partnerships.
All of our case studies can be found on our resources page.

"Thanks to the LSG team for your excellent service and support regarding this order."